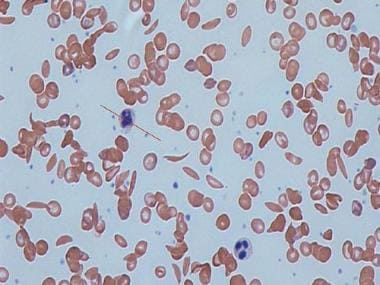

Symptoms of the disease are usually visible at the age of 5 months and change over time. Some of the common symptoms include pain, anaemia, frequent infections, swelling of hands and feet and vision problem
Sickle-shaped cells and normal blood cells in human blood. Image courtesy: Wikimedia Commons/Dr Graham Beards
World Sickle Cell Day is marked every year on 19 June with an aim to raise awareness about sickle cell disease. Sickle Cell Disease is a group of disorders that impact haemoglobin, the molecule in red blood cells which deliver oxygen to cells throughout the body.
Individuals who live with this disease have haemoglobin S, an atypical haemoglobin molecule which distorts red blood cells into a sickle or a crescent shape. The disease is usually transmitted from parents to children.
What are the symptoms?
Symptoms of the disease are usually visible at the age of 5 months and change over time. Some of the common symptoms include pain, anaemia, frequent infections, swelling of hands and feet and vision problem.
What are the different types of Sickle Cell Disease?
HbSS or sickle cell anemia refers to a severe kind of sickle cell disease, which occurs when a child inherits sickle cell gene from each of the parents.
HbSc happens when one of the parents has sickle cell gene and the other has a gene from an abnormal haemoglobin.
Hbs beta thalassemia happens when sickle cell gene is passed from one parent, while beta-thalassemia is passed on from the other.
If one of the parents has a problem gene, then the child will not have symptoms but will possess sickle cell trait.
What is the treatment?
The disease can be detected in an infant during the screening process of a newborn. In case, there is a family history of the Sickle Cell disease, it can even be diagnosed at the time of pregnancy.
The only way to cure it is either stem cell or a bone marrow transplant. The symptoms can also be dealt with the use of antibiotics, periodic blood transfusion, pain killers, and vaccinations.
Read all the Latest News, Trending News, Cricket News, Bollywood News,
India News and Entertainment News here. Follow us on Facebook, Twitter and Instagram.